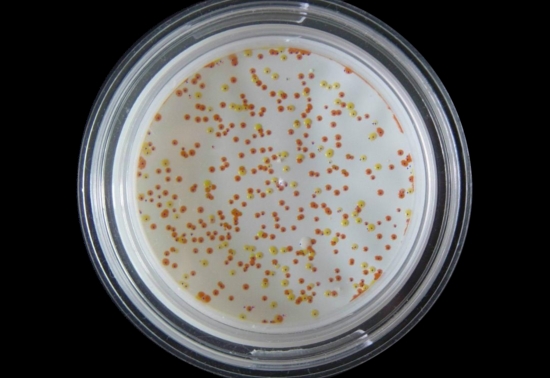
金黄色葡萄球菌

小心你家的冰箱成为杀手,孕妈妈要格外注意
家里冰箱还用的好好的根本不想换!可是很多健康隐患不得不纳入考虑范围。
冰箱在国内的普及率极高,绝大部分家庭都会有一台冰箱用以储存食材,这一方面小小的空间里,包含了瓜果蔬菜,鸡鸭鱼肉,还有一些熟食一品,几乎囊括了整个家庭日常饮食所需。
事实上有很多病菌冰箱没办法解决,比如以下这几种冰箱中主要的细菌,肉眼无法看到的小家伙实际上具有会很严重的危害。
金黄色葡萄球菌
金黄色葡萄球菌为一种常见的食源性致病微生物在,敞口牛奶、破损鸡蛋鸡蛋、冷冻的各种肉类都是他们能够繁衍生息的地方。适当的条件下,金黄色葡萄球菌会引起食物中毒,呕吐、腹泻、发热等是常见症状,且它引起的食物中毒问题占食源性微生物食物中毒事件的四分之一左右,甚至他还会通过破损的肌肤、感染的鼻眼进入人体。
李斯特菌
李斯特菌有着听着挺文雅的名字,但是个没有“感情的杀手”。豆芽、肉类熟食、烟熏海鲜类、软奶酪、未灭菌牛奶等都是它的繁殖基地,而且它还不怕冷,冰淇淋上也有它的踪迹。感染李斯特菌的症状有发热、肌肉痛、恶心、腹泻,重症者还会出现脑膜炎、败血症等。更可怕的是还会危及生命,甚至通过胎盘传染给胎儿,现实中因感染李斯特菌导致死胎情况不止一例!

沙门氏菌
据统计在世界各国的种类细菌性食物中毒中,沙门氏菌引起的食物中毒常列榜首。沙门氏菌喜欢寄生在鲜奶、禽类、鱼类、肉蛋上,在冰箱中可生存3-4个月。感染沙门氏菌会出现发热、头疼、、恶心、呕吐、腹痛、腹泻等症状,还伴有乏力、肌肉酸痛、视觉模糊、中等程度发热、躁动不安和嗜睡,像婴幼儿、老年人以及免疫系统较弱的人群都是它的目标。

除此之外,像大肠杆菌、耶尔森氏菌、志贺氏菌都是冰箱中潜伏的“危险分子”,特别是有婴幼儿的家庭一定要格外注意。特别是有异味的冰箱,很有可能就是细菌代谢产生的气体在作怪。
冰箱温度低,一定程度上确实能够延长食材寿命,但这一系列生命顽强的细菌并不会因此而走向灭亡。也正是如此,各品牌冰箱都会研发各类除菌保鲜新手段。但家中冰箱还能正常使用,换一台抑菌除菌的冰箱又动辄几千上万,不可能说换就换。如果您也是处于这样一种状况,不如考虑一下冰箱专用的空气净化器。

这类冰箱空气净化器主要采用臭氧除菌的方式。臭氧是一种强氧化剂,其杀菌效果通常是物理、化学、生物三个方面综合的结果。简单来说,针对于有细胞的细菌霉菌类,臭氧会破坏细胞膜、使细胞活动必需的酶失去活性以及破坏遗传物质的方式杀菌;针对病毒,则是直接破坏核糖核酸或脱氧核酸。经过科学家的各项试验可证明,臭氧的杀菌能力是毋庸置疑的。
而通过臭氧杀菌方式清理冰箱内部空气卫生的冰箱专用的空气净化器,正是通过臭氧来破坏细菌生物结构,实现杀死细菌,净专业机构检测,多种细菌的灭活率都高达99%以上。据了解,它还能有效还能够延长食物保质期、加快农残留讲解速度以及快速祛除异味,还冰箱一个洁净清新的储存环境。

因臭氧极不稳定,在冰箱中杀菌后会分解为氧气等洁净物质,无害无残留。但值得注意的是,杀灭细菌病毒对臭氧的浓度和时间都有一定的要求,笔者随机选取了三款口碑不错的产品,发现它们产生臭氧的浓度至少≤0.05ppm,甚至只小于0.1ppm。

而研究表明,空气中臭氧水平提高到0.05ppm,空气中臭氧浓度在0.012ppm水平时,能导致人皮肤刺痒,眼睛、鼻咽、呼吸道受刺激,肺功能受到影响,引起咳嗽、气短和胸痛等症状。所以笔者建议在冰箱专用空气净化器工作时,最好不要打开冰箱,好在它工作时间仅需30分钟,并不会对我们的生活造成影响。

加之冰箱专用空气净化器价格不过二三百元,且不是消耗品,可通过充电实现持续性使用,确实值得尝试。不过冰箱专用空气净化器虽然效果显著,但并不是万无一失的保障,所以我们日常使用冰箱还是要注意以下几点:
1、 定期清理冰箱:据了解,使用一年不清理的冰箱中细菌种类高达2970多种。
2、 冰箱不要塞得满满当当,留出充足的空间以使空气良好流通,保证制冷效果。
3、 注意食材不要混放,避免不同食材上的不同细菌交叉感染,特别注意生熟食混放问题!
无论如何,冰箱的食材储存安全问题万万不能忽视,这些肉眼看不见的细菌会在无形之中危害我们的健康。家中有老幼病人等体质差人群的家庭更要格外注意。如果你有什么冰箱食材储存的好方法,可以分享给大家哦~
下一篇:越来越多人关注家中水质问题,中国净水器市场发展现状如何?
返回首页